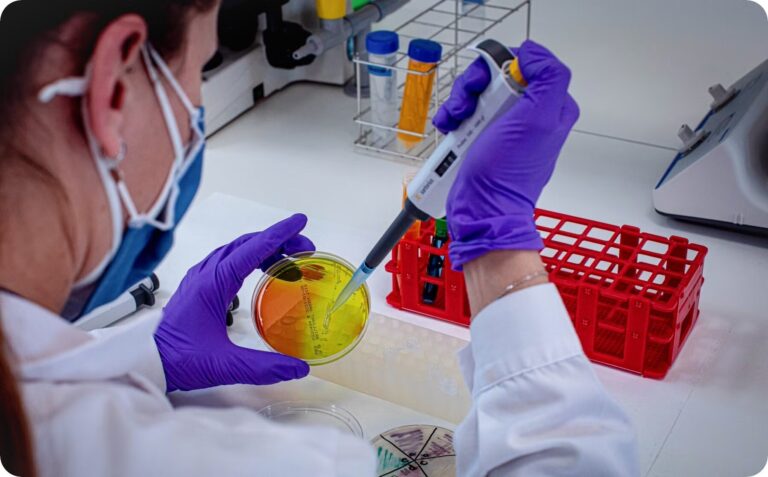

La biotecnología ya no es un concepto lejano reservado a laboratorios especializados. Cada día escuchamos sobre avances en salud, agricultura sostenible, biocombustibles o incluso en la creación de materiales biodegradables gracias a esta disciplina. Por ello, integrar la biotecnología en la escuela no es solo una opción innovadora, sino una necesidad para preparar a los estudiantes frente a los retos del futuro.
¿Por qué enseñar biotecnología desde la escuela?
La biotecnología combina áreas como biología, química, tecnología e ingeniería. Incluirla en la educación básica y media no solo permite que los alumnos conozcan aplicaciones reales de la ciencia, sino que también despierta en ellos el pensamiento crítico y la curiosidad por resolver problemas actuales: ¿cómo alimentar a una población creciente sin dañar el medio ambiente? ¿cómo diseñar medicinas más efectivas y accesibles?
Beneficios para los estudiantes
- Conexión con la vida real: los jóvenes comprenden cómo la ciencia impacta directamente en su vida cotidiana, desde los alimentos hasta los tratamientos médicos.
- Fomento de vocaciones científicas: se despierta el interés por carreras relacionadas con investigación, medicina, ingeniería genética o bioinformática.
- Habilidades del siglo XXI: promueve la creatividad, el trabajo en equipo y la capacidad de innovación.
- Conciencia ética y ambiental: enseña a reflexionar sobre los límites de la ciencia y la responsabilidad en su aplicación.
Cómo llevarla al aula
- Laboratorios virtuales y simulaciones: incluso sin equipos costosos, los estudiantes pueden experimentar procesos biotecnológicos en entornos digitales.
- Proyectos prácticos: desde cultivar plantas resistentes en el huerto escolar hasta diseñar propuestas para reducir residuos orgánicos mediante microorganismos.
- Colaboraciones externas: universidades y centros de investigación pueden acercar experiencias reales a los alumnos a través de charlas y talleres.
Mirando hacia adelante
Enseñar biotecnología en la escuela no significa que todos los estudiantes se conviertan en científicos, sino que aprendan a comprender y participar en un mundo donde la ciencia y la tecnología están cada vez más presentes. Desde hoy, sembrar ese interés puede marcar la diferencia en la manera en que la próxima generación enfrente los desafíos globales.
La biotecnología en la escuela no solo forma futuros profesionales, también forma ciudadanos capaces de entender, cuestionar y aprovechar responsablemente los avances científicos.